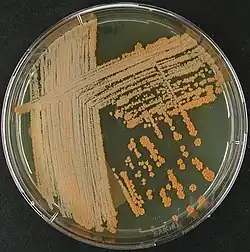

Tsukamurella
| Tsukamurella | ||
|---|---|---|
![]() | ||
| Taxonomía | ||
| Dominio: | Bacteria | |
| Reino: | Bacillati | |
| Filo: | Actinomycetota | |
| Clase: | Actinomycetes | |
| Orden: | Mycobacteriales | |
| Familia: |
Tsukamurellaceae Rainey et al. 1997 | |
| Género: |
Tsukamurella Collins et al. 1988 | |
| Especies | ||
Tsukamurella es un género de bacterias grampositivas, el único de la familia Tsukamurellaceae. Se trata de un grupo de bacterias en forma de bacilos, aerobias, parcialmente ácido-alcohol resistentes, muy relacionadas con los géneros Gordonia, Nocardia, Corynebacterium, Rhodococcus y Williamsia. Tiene una distribución ubicua, encontrándose tanto en suelos como en aguas y en ambientes muy diversos del planeta. Además, algunas especies pueden producir infecciones en humanos, principalmente bacteriemia e infecciones oculares, aunque es un microorganismo muy poco frecuente en la clínica.
Historia
El primer aislamiento documentado de esta bacteria fue en 1941, a partir de un micetoma y ovarios de chinches de cama (Ciex lectularius), y se describió como Corynebacterium paurometabolum.[1] Posteriormente, también se denominó Gordona aurantiaca tras ser aislada del esputo de pacientes con enfermedad pulmonar crónica,[2][3] y más tarde se describió como agente patógeno.[4] También ha recibido el nombre de Rhodococcus aurantiacus, hasta que finalmente, en 1988 se unificaron bajo el nombre de Tsukamurella paurometabola, en honor al microbiólogo japonés Michio Tsukamura.[5] Entre las especies que forman este género, se han producido otros cambios taxonómicos como en la especie Tsukamurella wratislaviensis, que se reclasificó al género Rhodococcus.[6]
Taxonomía
Actualmente hay 16 especies descritas con la taxonomía bien establecida y 13 de ellas se han descrito como causantes de infecciones en humanos.
- Tsukamurella asaccharolytica Teng et al. 2020
- Tsukamurella conjunctivitidis Teng et al. 2020
- Tsukamurella hominis Teng et al. 2018
- Tsukamurella hongkongensis Teng et al. 2016
- Tsukamurella inchonensis Yassin et al. 1995
- Tsukamurella ocularis Teng et al. 2018
- Tsukamurella paurometabola corrig. (Steinhaus 1941) Collins et al. 1988
- Tsukamurella pseudospumae Nam et al. 2004
- Tsukamurella pulmonis Yassin et al. 1996
- Tsukamurella serpentis Tang et al. 2016
- Tsukamurella sinensis Teng et al. 2016
- Tsukamurella soli Weon et al. 2010
- Tsukamurella spumae Nam et al. 2003
- Tsukamurella sputi Teng et al. 2020
- Tsukamurella strandjordii corrig. Kattar et al. 2002
- Tsukamurella tyrosinosolvens Yassin et al. 1997
Clínica
Las infecciones humanas más comunes están relacionadas sobre todo con bacteriemia asociada a catéteres[7][8][9][10] e infecciones oculares como conjuntivitis y queratitis.[11][12] Además, se han notificado casos de infecciones relacionadas con implantes[13] y prótesis de rodilla,[14] peritonitis,[15][16] otitis,[9][17] neumonía[18][19][20] y un caso de meningitis.[21] Además, también se ha descrito un brote en una clínica oncológica posiblemente causado por contaminación de una solución salina.[22]
Se puede diagnosticar fácilmente a nivel de especie mediante secuenciación del gen groEL,[23] aunque también es útil para muchas especies el gen 16S rRNA y el secA1,[24] así como por MALDI-TOF MS.[25][26][27]
El tratamiento óptimo no está claro ya que son infecciones poco comunes.[28][29] La terapia antimicrobiana más usada suele ser una combinación de beta-lactámicos y aminoglucósidos, aunque en casos de bacteriemia por catéter, la retirada de éste suele ser esencial. Se ha observado susceptibilidad a sulfametoxazol, imipenem, cefalosporinas de tercera generación, amikacina y ciprofloxacino, pero resistencia a penicilinas y cefalosporinas de segunda generación.[30] En otros casos se han tratado estas infecciones de forma exitosa con eritromicina y gentamicina,[31] con vancomicina,[32] y con piperaciclina-tazobactam, claritromicina, ciprofloxacino y etambutol. Por otro lado, se ha descrito que Tsukamurella modifica la rifampicina por ribosilación del grupo 23-OH del antibiótico.[33]
Aislamientos en animales y plantas
En animales hay pocos casos notificados, siendo aislada de la cavidad oral de cobras chinas,[34] de la boca de moscas hematófagas africanas (Glossina palpalis),[35] del grillo topo del sur (Scapteriscus borrellii),[36] del ácaro rojo de las gallinas (Dermanyssus gallinae),[37] de pitón[38] y de ciervo.[39] También se han aislado cepas a partir de plantas como Dracaena cochinchinensis[40] y de raíces.[41]
Hábitat
Tsukamurella es una bacteria ubicua, distribuida en gran diversidad de ambientes. Así, se ha aislado de ambientes terrestres[42] y aguas residuales,[43] en el suelo de la Antártida[44] y en sedimentos marinos.[45][46] Además, Tsukamurella se encuentra en lodos de plantas de tratamiento de fangos, y se han aislado bacteriófagos de este género con el objetivo de controlar la acumulación de espuma en estas plantas.[47]
Referencias
- ↑ Steinhaus, Edward A. (1941-12). «A Study of the Bacteria Associated with Thirty Species of Insects». Journal of Bacteriology (en inglés) 42 (6): 757-790. ISSN 0021-9193. PMC 374792. PMID 16560484. doi:10.1128/jb.42.6.757-790.1941. Consultado el 13 de agosto de 2022.
- ↑ Tsukamura, M.; Mizuno, S. (1971-04). «[A new species Gordona aurantiaca occurring in sputa of patients with pulmonary disease]». Kekkaku: [Tuberculosis] (en japonés) 46 (4): 93-98. ISSN 0022-9776. PMID 5572851. Consultado el 13 de agosto de 2022.
- ↑ Tsukamura, M. (1971-09). «Proposal of a new genus, Gordona, for slightly acid-fast organisms occurring in sputa of patients with pulmonary disease and in soil». Journal of General Microbiology (en inglés) 68 (1): 15-26. ISSN 0022-1287. PMID 4109926. doi:10.1099/00221287-68-1-15. Consultado el 13 de agosto de 2022.
- ↑ Tsukamura, M.; Kawakami, K. (1982-10). «Lung infection caused by Gordona aurantiaca (Rhodococcus aurantiacus)». Journal of Clinical Microbiology (en inglés) 16 (4): 604-607. ISSN 0095-1137. PMC 272430. PMID 7153308. doi:10.1128/jcm.16.4.604-607.1982. Consultado el 13 de agosto de 2022.
- ↑ COLLINS, M. D.; SMIDA, J.; DORSCH, M.; STACKEBRANDT, E.YR 1988. «Tsukamurella gen. nov. Harboring Corynebacterium paurometabolum and Rhodococcus aurantiacus». International Journal of Systematic and Evolutionary Microbiology (en inglés) 38 (4): 385-391. ISSN 1466-5034. doi:10.1099/00207713-38-4-385. Consultado el 13 de agosto de 2022.
- ↑ Goodfellow, Michael; Chun, Jongsik; Stackebrandt, Erko; Kroppenstedt, Reiner M. (2002-05). «Transfer of Tsukamurella wratislaviensis Goodfellow et a. 1995 to the genus Rhodococcus as Rhodococcus wratislaviensis comb. nov.». International Journal of Systematic and Evolutionary Microbiology (en inglés) 52 (Pt 3): 749-755. ISSN 1466-5026. PMID 12054234. doi:10.1099/00207713-52-3-749. Consultado el 13 de agosto de 2022.
- ↑ Schwartz, M. A.; Tabet, S. R.; Collier, A. C.; Wallis, C. K.; Carlson, L. C.; Nguyen, T. T.; Kattar, M. M.; Coyle, M. B. (1 de octubre de 2002). «Central venous catheter-related bacteremia due to Tsukamurella species in the immunocompromised host: a case series and review of the literature». Clinical Infectious Diseases: An Official Publication of the Infectious Diseases Society of America (en inglés) 35 (7): e72-77. ISSN 1537-6591. PMID 12228839. doi:10.1086/342561. Consultado el 13 de agosto de 2022.
- ↑ Bouza, E.; Pérez-Parra, A.; Rosal, M.; Martín-Rabadán, P.; Rodríguez-Créixems, M.; Marín, M. (2009-02). «Tsukamurella: a cause of catheter-related bloodstream infections». European Journal of Clinical Microbiology & Infectious Diseases: Official Publication of the European Society of Clinical Microbiology (en inglés) 28 (2): 203-210. ISSN 1435-4373. PMID 18810513. doi:10.1007/s10096-008-0607-2. Consultado el 13 de agosto de 2022.
- ↑ a b Liu, Chia-Ying; Lai, Chih-Cheng; Lee, Meng-Rui; Lee, Yi-Chieh; Huang, Yu-Tsung; Liao, Chun-Hsing; Hsueh, Po-Ren (2011-12). «Clinical characteristics of infections caused by Tsukamurella spp. and antimicrobial susceptibilities of the isolates». International Journal of Antimicrobial Agents (en inglés) 38 (6): 534-537. ISSN 1872-7913. PMID 22014886. doi:10.1016/j.ijantimicag.2011.07.018. Consultado el 13 de agosto de 2022.
- ↑ Wendorf, Kristen A.; Espinosa, Claudia M.; Lebar, William D.; Weinberg, Jason B. (3 de febrero de 2010). «Tsukamurella catheter-related bloodstream infection in a pediatric patient with pulmonary hypertension». Infectious Disease Reports (en inglés) 2 (1): e5. ISSN 2036-7430. PMC 3892576. PMID 24470887. doi:10.4081/idr.2010.e5. Consultado el 13 de agosto de 2022.
- ↑ Woo, Patrick C. Y.; Ngan, Antonio H. Y.; Lau, Susanna K. P.; Yuen, Kwok-Yung (2003-07). «Tsukamurella conjunctivitis: a novel clinical syndrome». Journal of Clinical Microbiology (en inglés) 41 (7): 3368-3371. ISSN 0095-1137. PMC 165315. PMID 12843095. doi:10.1128/JCM.41.7.3368-3371.2003. Consultado el 13 de agosto de 2022.
- ↑ Tam, Patrick M. K.; Young, Alvin L.; Cheng, Lulu; Congdon, Nathan; Lam, Philip T. H. (2010-03). «Tsukamurella: an unrecognized mimic of atypical mycobacterial keratitis? The first case report». Cornea (en inglés) 29 (3): 362-364. ISSN 1536-4798. PMID 20098312. doi:10.1097/ICO.0b013e3181ae2594. Consultado el 13 de agosto de 2022.
- ↑ Almehmi, Ammar; Pfister, Alfred K.; McCowan, Ronald; Matulis, Susie (2004-09). «Implantable cardioverter-defibrillator infection caused by Tsukamurella». The West Virginia Medical Journal (en inglés) 100 (5): 185-186. ISSN 0043-3284. PMID 15617463. Consultado el 13 de agosto de 2022.
- ↑ Larkin, J. A.; Lit, L.; Sinnott, J.; Wills, T.; Szentivanyi, A. (1999-08). «Infection of a knee prosthesis with Tsukamurella species». Southern Medical Journal (en inglés) 92 (8): 831-832. ISSN 0038-4348. PMID 10456728. doi:10.1097/00007611-199908000-00019. Consultado el 13 de agosto de 2022.
- ↑ Shaer, A. J.; Gadegbeku, C. A. (2001-09). «Tsukamurella peritonitis associated with continuous ambulatory peritoneal dialysis». Clinical Nephrology (en inglés) 56 (3): 241-246. ISSN 0301-0430. PMID 11597040. Consultado el 13 de agosto de 2022.
- ↑ Ismayilov, Rashad; Duran, Zeynep Cansu; Hazirolan, Gulsen; Inkaya, Ahmet Çagkan (2021-10). «Tsukamurella paurometabola peritonitis in a patient on automated peritoneal dialysis». Enfermedades Infecciosas Y Microbiologia Clinica (English Ed.) (en inglés) 39 (8): 422. ISSN 2529-993X. PMID 34620478. doi:10.1016/j.eimce.2020.10.010. Consultado el 13 de agosto de 2022.
- ↑ Sheng, Wang-Huei; Huang, Yu-Tsung; Chang, Shan-Chwen; Hsueh, Po-Ren (2009-05). «Brain abscess caused by Tsukamurella tyrosinosolvens in an immunocompetent patient». Journal of Clinical Microbiology (en inglés) 47 (5): 1602-1604. ISSN 1098-660X. PMC 2681870. PMID 19297591. doi:10.1128/JCM.01932-08. Consultado el 13 de agosto de 2022.
- ↑ Alcaide, Maria Luisa; Espinoza, Luis; Abbo, Lilian (2004-07). «Cavitary pneumonia secondary to Tsukamurella in an AIDS patient. First case and a review of the literature». The Journal of Infection (en inglés) 49 (1): 17-19. ISSN 0163-4453. PMID 15194243. doi:10.1016/S0163-4453(03)00139-7. Consultado el 13 de agosto de 2022.
- ↑ Mehta, Yatin B.; Goswami, Raktima; Bhanot, Nitin; Mehta, Zankhana; Simonelli, Paul (2011-06). «Tsukamurella infection: a rare cause of community-acquired pneumonia». The American Journal of the Medical Sciences (en inglés) 341 (6): 500-503. ISSN 1538-2990. PMID 21613935. doi:10.1097/MAJ.0b013e3182129d02. Consultado el 13 de agosto de 2022.
- ↑ Savini, Vincenzo; Fazii, Paolo; Favaro, Marco; Astolfi, Daniela; Polilli, Ennio; Pompilio, Arianna; Vannucci, Mariangela; D'Amario, Claudio et al. (2012-05). «Tuberculosis-like pneumonias by the aerobic actinomycetes Rhodococcus, Tsukamurella and Gordonia». Microbes and Infection (en inglés) 14 (5): 401-410. ISSN 1769-714X. PMID 22192786. doi:10.1016/j.micinf.2011.11.014. Consultado el 13 de agosto de 2022.
- ↑ Prinz, G.; Bán, E.; Fekete, S.; Szabó, Z. (1985-09). «Meningitis caused by Gordona aurantiaca (Rhodococcus aurantiacus)». Journal of Clinical Microbiology (en inglés) 22 (3): 472-474. ISSN 0095-1137. PMC 268441. PMID 4044805. doi:10.1128/jcm.22.3.472-474.1985. Consultado el 13 de agosto de 2022.
- ↑ See, Isaac; Nguyen, Duc B.; Chatterjee, Somu; Shwe, Thein; Scott, Melissa; Ibrahim, Sherif; Moulton-Meissner, Heather; McNulty, Steven et al. (2014-03). «Outbreak of Tsukamurella species bloodstream infection among patients at an oncology clinic, West Virginia, 2011-2012». Infection Control and Hospital Epidemiology (en inglés) 35 (3): 300-306. ISSN 1559-6834. PMC 4830385. PMID 24521597. doi:10.1086/675282. Consultado el 13 de agosto de 2022.
- ↑ Teng, Jade L. L.; Tang, Ying; Chiu, Tsz Ho; Cheung, Candy L. W.; Ngan, Antonio H. Y.; Ngai, Cheung; Wong, Samson S. Y.; Que, Tak-Lun et al. (2017-02). «The groEL Gene Is a Promising Target for Species-Level Identification of Tsukamurella». Journal of Clinical Microbiology (en inglés) 55 (2): 649-653. ISSN 1098-660X. PMC 5277538. PMID 27974536. doi:10.1128/JCM.02260-16. Consultado el 13 de agosto de 2022.
- ↑ Perez Del Molino Bernal, Inmaculada C.; Agüero Balbin, Jesus (2017-05). «seqA1 Is a Useful Target for Identification of Tsukamurella pulmonis». Journal of Clinical Microbiology (en inglés) 55 (5): 1591. ISSN 1098-660X. PMC 5405279. PMID 28442612. doi:10.1128/JCM.00198-17. Consultado el 13 de agosto de 2022.
- ↑ Teng, Jade L. L.; Tang, Ying; Wong, Samson S. Y.; Fong, Jordan Y. H.; Zhao, Zhe; Wong, Chun-Pong; Chen, Jonathan H. K.; Ngan, Antonio H. Y. et al. (9 de mayo de 2018). «MALDI-TOF MS for identification of Tsukamurella species: Tsukamurella tyrosinosolvens as the predominant species associated with ocular infections». Emerging Microbes & Infections (en inglés) 7 (1): 80. ISSN 2222-1751. PMC 5940693. PMID 29739926. doi:10.1038/s41426-018-0083-4. Consultado el 13 de agosto de 2022.
- ↑ Hsueh, Po-Ren; Lee, Tai-Fen; Du, Shin-Hei; Teng, Shih-Hua; Liao, Chun-Hsing; Sheng, Wang-Hui; Teng, Lee-Jene (2014-07). «Bruker biotyper matrix-assisted laser desorption ionization-time of flight mass spectrometry system for identification of Nocardia, Rhodococcus, Kocuria, Gordonia, Tsukamurella, and Listeria species». Journal of Clinical Microbiology (en inglés) 52 (7): 2371-2379. ISSN 1098-660X. PMC 4097692. PMID 24759706. doi:10.1128/JCM.00456-14. Consultado el 13 de agosto de 2022.
- ↑ Yarbrough, Melanie L.; Lainhart, William; Burnham, Carey-Ann D. (2017-10). «Identification of Nocardia, Streptomyces, and Tsukamurella using MALDI-TOF MS with the Bruker Biotyper». Diagnostic Microbiology and Infectious Disease (en inglés) 89 (2): 92-97. ISSN 1879-0070. PMID 28811116. doi:10.1016/j.diagmicrobio.2017.06.019. Consultado el 13 de agosto de 2022.
- ↑ Safaei, S.; Fatahi-Bafghi, M.; Pouresmaeil, Omid (2018-03). «Role of Tsukamurella species in human infections: first literature review». New Microbes and New Infections (en inglés) 22: 6-12. ISSN 2052-2975. PMC 5857166. PMID 29556401. doi:10.1016/j.nmni.2017.10.002. Consultado el 13 de agosto de 2022.
- ↑ Salar-Vidal, Llanos; Martín-García, Marta; Macías-Valcayo, Alicia; Ponz, Ana; Esteban, Jaime (31 de marzo de 2021). «Epidemiology and in vitro antimicrobial susceptibility of aerobic Actinomycetales in a clinical setting». Enfermedades Infecciosas Y Microbiologia Clinica (English Ed.) (en inglés): S0213-005X(21)00075-6. ISSN 2529-993X. PMID 33812738. doi:10.1016/j.eimc.2021.02.010. Consultado el 13 de agosto de 2022.
- ↑ Shapiro, C. L.; Haft, R. F.; Gantz, N. M.; Doern, G. V.; Christenson, J. C.; O'Brien, R.; Overall, J. C.; Brown, B. A. et al. (1992-01). «Tsukamurella paurometabolum: a novel pathogen causing catheter-related bacteremia in patients with cancer». Clinical Infectious Diseases: An Official Publication of the Infectious Diseases Society of America (en inglés) 14 (1): 200-203. ISSN 1058-4838. PMID 1571430. doi:10.1093/clinids/14.1.200. Consultado el 13 de agosto de 2022.
- ↑ Lai, K. K. (1993-08). «A cancer patient with central venous catheter-related sepsis caused by Tsukamurella paurometabolum (Gordona aurantiaca)». Clinical Infectious Diseases: An Official Publication of the Infectious Diseases Society of America (en inglés) 17 (2): 285-287. ISSN 1058-4838. PMID 8399886. doi:10.1093/clinids/17.2.285-a. Consultado el 13 de agosto de 2022.
- ↑ Jones, R. S.; Fekete, T.; Truant, A. L.; Satishchandran, V. (1994-05). «Persistent bacteremia due to Tsukamurella paurometabolum in a patient undergoing hemodialysis: case report and review». Clinical Infectious Diseases: An Official Publication of the Infectious Diseases Society of America (en inglés) 18 (5): 830-832. ISSN 1058-4838. PMID 8075284. doi:10.1093/clinids/18.5.830. Consultado el 13 de agosto de 2022.
- ↑ Tanaka, Y.; Yazawa, K.; Dabbs, E. R.; Nishikawa, K.; Komaki, H.; Mikami, Y.; Miyaji, M.; Morisaki, N. et al. (1996). «Different rifampicin inactivation mechanisms in Nocardia and related taxa». Microbiology and Immunology (en inglés) 40 (1): 1-4. ISSN 0385-5600. PMID 8871521. doi:10.1111/j.1348-0421.1996.tb03303.x. Consultado el 13 de agosto de 2022.
- ↑ Tang, Ying; Teng, Jade L. L.; Cheung, Candy L. W.; Ngan, Antonio H. Y.; Huang, Yi; Wong, Samson S. Y.; Yip, Eric K. T.; Ng, Kenneth H. L. et al. (2016-09). «Tsukamurella serpentis sp. nov., isolated from the oral cavity of Chinese cobras (Naja atra)». International Journal of Systematic and Evolutionary Microbiology (en inglés) 66 (9): 3329-3336. ISSN 1466-5034. PMID 27257031. doi:10.1099/ijsem.0.001187. Consultado el 13 de agosto de 2022.
- ↑ Tsagmo Ngoune, Jean Marc; Reveillaud, Julie; Sempere, Guilhem; Njiokou, Flobert; Melachio, Trésor T.; Abate, Luc; Tchioffo, Majoline T.; Geiger, Anne (2 de abril de 2019). «The composition and abundance of bacterial communities residing in the gut of Glossina palpalis palpalis captured in two sites of southern Cameroon». Parasites & Vectors (en inglés) 12 (1): 151. ISSN 1756-3305. PMC 6444424. PMID 30940213. doi:10.1186/s13071-019-3402-2. Consultado el 13 de agosto de 2022.
- ↑ Aryal, Sudarshan K.; Carter-House, Derreck; Stajich, Jason E.; Dillman, Adler R. (2017-11). «Microbial associates of the southern mole cricket (Scapteriscus borellii) are highly pathogenic». Journal of Invertebrate Pathology (en inglés) 150: 54-62. ISSN 1096-0805. PMID 28916147. doi:10.1016/j.jip.2017.09.008. Consultado el 13 de agosto de 2022.
- ↑ Hubert, Jan; Erban, Tomas; Kopecky, Jan; Sopko, Bruno; Nesvorna, Marta; Lichovnikova, Martina; Schicht, Sabine; Strube, Christina et al. (2017-11). «Comparison of Microbiomes between Red Poultry Mite Populations (Dermanyssus gallinae): Predominance of Bartonella-like Bacteria». Microbial Ecology (en inglés) 74 (4): 947-960. ISSN 1432-184X. PMID 28534089. doi:10.1007/s00248-017-0993-z. Consultado el 13 de agosto de 2022.
- ↑ Maeda, Y.; Stanley, T.; Stirling, J.; Griffiths, M.; Calvert, A.; Stuart Elborn, J.; Cherie Millar, B.; Goldsmith, C. E. et al. (2010-12). «No evidence of transmission of bacteria between reptiles and a CF patient--a case report of a young adult CF patient and reptiles». Zoonoses and Public Health (en inglés) 57 (7-8): e47-53. ISSN 1863-2378. PMID 19968847. doi:10.1111/j.1863-2378.2009.01293.x. Consultado el 13 de agosto de 2022.
- ↑ Chen, Xiu (2014). «Diversity, Bioactivity and Drug Development of Cultivable Actinobacteria in Six Species of Bird Feces». American Journal of BioScience (en inglés) 2 (1): 13. ISSN 2330-0159. doi:10.11648/j.ajbio.20140201.13. Consultado el 13 de agosto de 2022.
- ↑ Salam, Nimaichand; Khieu, Thi-Nhan; Liu, Min-Jiao; Vu, Thu-Trang; Chu-Ky, Son; Quach, Ngoc-Tung; Phi, Quyet-Tien; Narsing Rao, Manik Prabhu et al. (2017). «Endophytic Actinobacteria Associated with Dracaena cochinchinensis Lour.: Isolation, Diversity, and Their Cytotoxic Activities». BioMed Research International (en inglés) 2017: 1308563. ISSN 2314-6141. PMC 5397652. PMID 28484706. doi:10.1155/2017/1308563. Consultado el 13 de agosto de 2022.
- ↑ Kim, Tae-Ui; Cho, Sung-Heun; Han, Ji-Hye; Shin, Young Min; Lee, Hyang Burm; Kim, Seung Bum (2012-02). «Diversity and physiological properties of root endophytic actinobacteria in native herbaceous plants of Korea». Journal of Microbiology (Seoul, Korea) (en inglés) 50 (1): 50-57. ISSN 1976-3794. PMID 22367937. doi:10.1007/s12275-012-1417-x. Consultado el 13 de agosto de 2022.
- ↑ Reyes, Ruth D. Hernández; Cafaro, Matías J. (2015-01). «Paratrechina longicornis ants in a tropical dry forest harbor specific Actinobacteria diversity». Journal of Basic Microbiology (en inglés) 55 (1): 11-21. ISSN 1521-4028. PMID 24771570. doi:10.1002/jobm.201300785. Consultado el 13 de agosto de 2022.
- ↑ Soler, Albert; García-Hernández, Jorge; Zornoza, Andrés; Alonso, José Luis (2018-01). «Diversity of culturable nocardioform actinomycetes from wastewater treatment plants in Spain and their role in the biodegradability of aromatic compounds». Environmental Technology (en inglés) 39 (2): 172-181. ISSN 1479-487X. PMID 28264640. doi:10.1080/09593330.2017.1296897. Consultado el 13 de agosto de 2022.
- ↑ Silva, Leonardo Jose; Crevelin, Eduardo José; Souza, Danilo Tosta; Lacerda-Júnior, Gileno Vieira; de Oliveira, Valeria Maia; Ruiz, Ana Lucia Tasca Gois; Rosa, Luiz Henrique; Moraes, Luiz Alberto Beraldo et al. (17 de agosto de 2020). «Actinobacteria from Antarctica as a source for anticancer discovery». Scientific Reports (en inglés) 10 (1): 13870. ISSN 2045-2322. PMC 7431910. PMID 32807803. doi:10.1038/s41598-020-69786-2. Consultado el 13 de agosto de 2022.
- ↑ Pathom-Aree, Wasu; Stach, James E. M.; Ward, Alan C.; Horikoshi, Koki; Bull, Alan T.; Goodfellow, Michael (2006-06). «Diversity of actinomycetes isolated from Challenger Deep sediment (10,898 m) from the Mariana Trench». Extremophiles: Life Under Extreme Conditions (en inglés) 10 (3): 181-189. ISSN 1431-0651. PMID 16538400. doi:10.1007/s00792-005-0482-z. Consultado el 13 de agosto de 2022.
- ↑ Ulanova, Dana; Goo, Kian-Sim (2015-05). «Diversity of actinomycetes isolated from subseafloor sediments after prolonged low-temperature storage». Folia Microbiologica (en inglés) 60 (3): 211-216. ISSN 1874-9356. PMID 25381631. doi:10.1007/s12223-014-0361-z. Consultado el 13 de agosto de 2022.
- ↑ Petrovski, Steve; Seviour, Robert J.; Tillett, Daniel (2011-02). «Genome sequence and characterization of the Tsukamurella bacteriophage TPA2». Applied and Environmental Microbiology (en inglés) 77 (4): 1389-1398. ISSN 1098-5336. PMC 3067230. PMID 21183635. doi:10.1128/AEM.01938-10. Consultado el 13 de agosto de 2022.